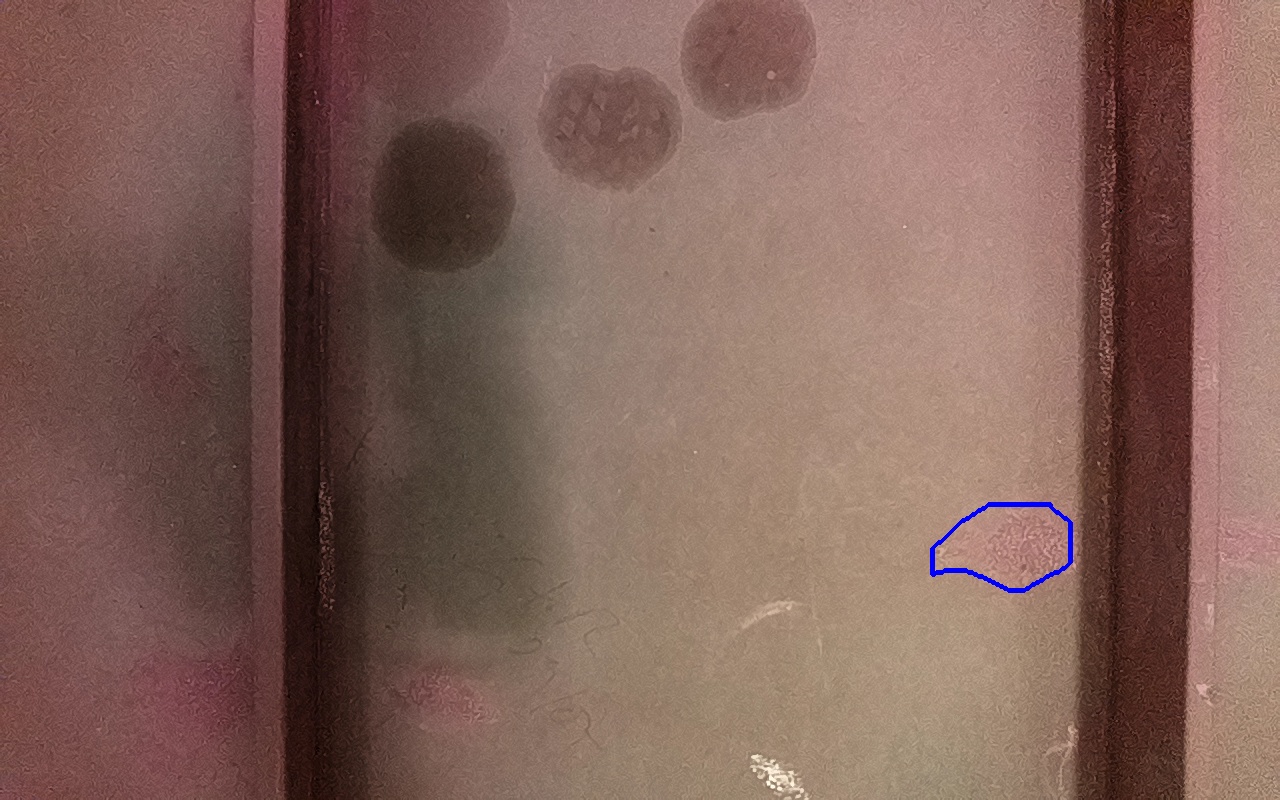
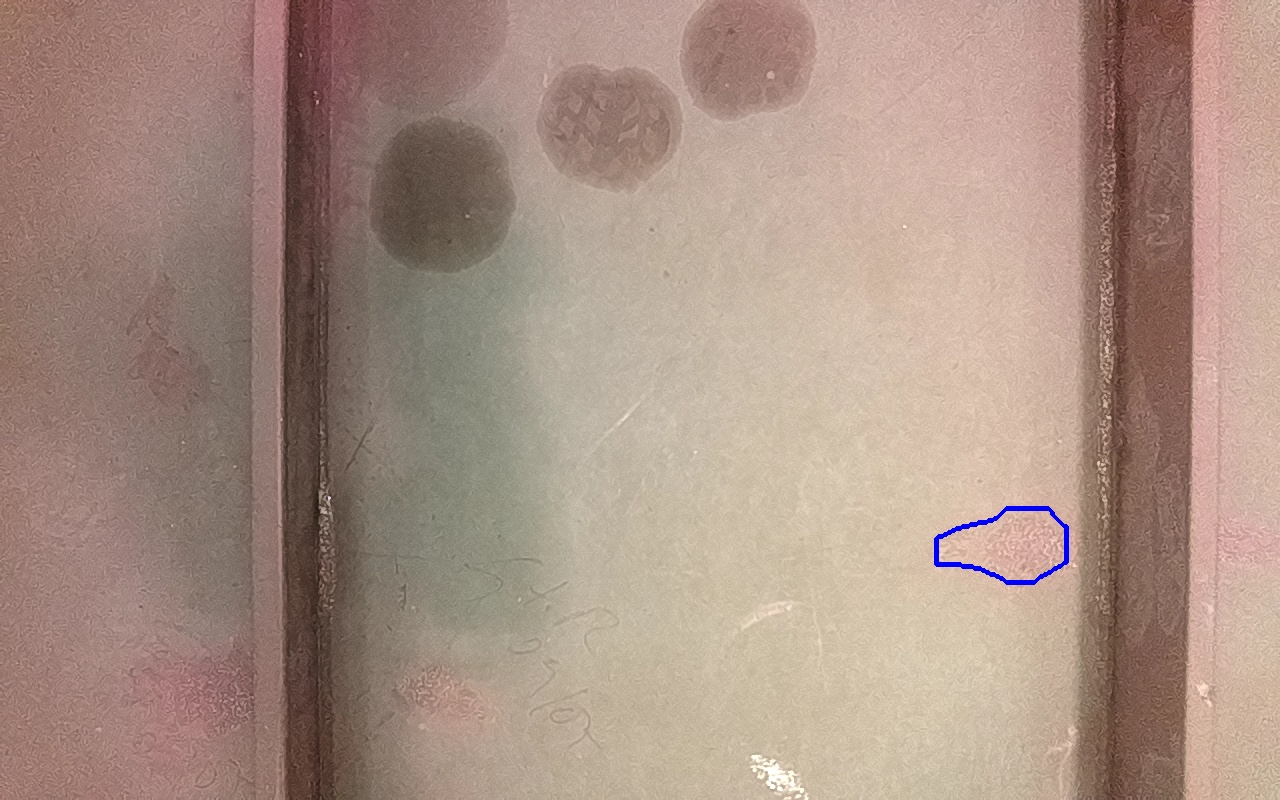

Proviene de:
IV-1B
ID: 256412
Confianza: 2.22 %
5621 mm2
(x: 2.53, y: -0.39, z: 0.01)
Rayaduras o zonas de metal expuestas con productos de óxido débilmente adherido.
Incluído en discontinuidad final: 266043
IV-1B
ID: 256419
Confianza: 21.11 %
4472 mm2
(x: 2.53, y: -0.39, z: 0.01)
Rayaduras o zonas de metal expuestas con productos de óxido débilmente adherido.
Incluído en discontinuidad final: 266043
IV-1B
ID: 256430

Confianza: 66.53 %
5751 mm2
(x: 2.53, y: -0.41, z: 0.0)
Rayaduras o zonas de metal expuestas con productos de óxido débilmente adherido.
Incluído en discontinuidad final: 266043
IV-1B
ID: 256439

Confianza: 66.3 %
5617 mm2
(x: 2.53, y: -0.41, z: 0.0)
Rayaduras o zonas de metal expuestas con productos de óxido débilmente adherido.
Incluído en discontinuidad final: 266043
Discontinuidad detectada
| Tipo |
IV-5
Daños por procesos térmicos donde el RPT se degrada dejando material que no está firmemente adherido. |
|---|---|
| Fecha | 26/06/2025 17:30 |
| Tamaño (mm) | 5751 mm2 |
| Tamaño (m) | 0.0058 m2 |
| Confianza | 66.53 % |
| Posición |
X: 2.53 Y: -0.4 Z: 0.01 |
